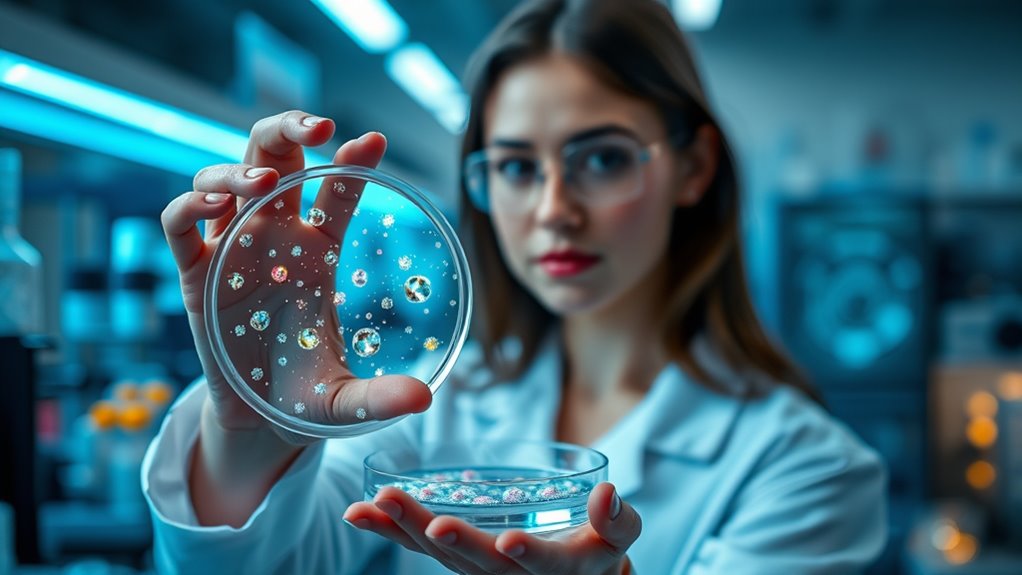
targeted senolytic nanoparticle delivery

Nanotech is rapidly advancing ways to repair cells, clear out aging cells, and build new tissues or organs, all aiming to extend lifespan. It uses targeted nanoparticles to deliver genetic tools, remove senescent cells, and support tissue regeneration, potentially slowing or reversing aging effects. While these innovations show promise, true immortality remains uncertain due to safety and ethical challenges. If you’re curious about how these technologies might transform your future, there’s much more to explore.
Key Takeaways
- Nanotech enables targeted delivery of genetic tools and repair materials to address cellular aging and tissue degeneration.
- It facilitates tissue regeneration through nanoscale scaffolds, promoting organ repair and functional restoration.
- Nanodevices can detect and clear senescent cells, potentially reversing age-related tissue decline.
- Nanotech enhances immune system rejuvenation and pathogen defense, supporting overall health span.
- While promising, nanotech alone is not currently capable of achieving biological immortality; it aims to significantly extend healthy lifespan.

Nanoparticle Drug Delivery Systems for Cancer Treatment
As an affiliate, we earn on qualifying purchases.
As an affiliate, we earn on qualifying purchases.
How Nanoparticles Are Targeting Cellular Damage

Nanoparticles are revolutionizing how we address cellular damage by delivering targeted therapies directly to affected cells. You can think of them as tiny delivery trucks that transport genetic tools like CRISPR or mRNA straight to problematic cells, fixing mutations or restoring damaged pathways. Lipid nanoparticles, similar to those used in mRNA vaccines, provide a practical way to deliver nucleic acids for cell repair and reprogramming. Biodegradable polymeric nanoparticles release small molecules such as senolytics or NAD+ precursors slowly, reaching tissues like the brain or cartilage that usually resist drug penetration. Surface modifications, like attaching antibodies or peptides, help these nanocarriers target specific cell types—hepatocytes, neurons, muscle stem cells—reducing off-target effects. This precision opens new doors for repairing cellular damage, extending healthy lifespan. Advances in nanoparticle targeting are enhancing the ability to direct these therapies with even greater accuracy, minimizing side effects and improving outcomes.

Advanced Drug Delivery Systems in Management of Chronic Obstructive Pulmonary Disease
As an affiliate, we earn on qualifying purchases.
As an affiliate, we earn on qualifying purchases.
Intracellular Sensors and Real-Time Aging Diagnostics

Intracellular sensors and real-time diagnostics are transforming how you monitor aging processes by providing immediate, precise insights into cellular health. These nanodevices detect biomarkers like DNA damage, senescence signals, and oxidative stress within your cells, enabling early intervention. Nanosensors in circulation or tissues measure composite aging indicators, offering a dynamic view of your biological age rather than relying on static metrics. When integrated with wearable or implantable systems, they create closed-loop platforms that trigger targeted therapies automatically when harmful changes are detected. This real-time feedback improves treatment precision and timing, potentially slowing aging progression. Despite manufacturing challenges and limited long-term data, these nanodiagnostics hold promise for personalized aging management, moving us closer to proactive, cellular-level longevity strategies. Advances in biomarker detection are essential for refining these technologies and expanding their clinical applications. Additionally, ongoing research into nanomaterial biocompatibility aims to address safety concerns and improve the durability of these diagnostic tools. Moreover, the development of high-throughput screening methods accelerates the discovery of new biomarkers crucial for enhancing nanodiagnostic capabilities. Furthermore, understanding the net worth of notable figures in related fields can foster interdisciplinary innovations that enhance nanotechnology applications. Emerging innovations in molecular engineering are also expected to enhance the sensitivity and specificity of intracellular sensors, enabling even earlier detection of cellular aging processes.
biodegradable nanocarriers for tissue repair
As an affiliate, we earn on qualifying purchases.
As an affiliate, we earn on qualifying purchases.
Clearing Senescent Cells to Rejuvenate Tissues
As we age, senescent cells accumulate in tissues, releasing inflammatory signals that impair function and drive age-related decline. Nanotech offers a targeted way to clear these cells, improving tissue health. Nanoparticles can deliver senolytics or siRNA directly to senescent cells, exploiting markers like uPAR or beta-galactosidase for selective uptake. This reduces collateral damage to healthy cells and minimizes side effects. Combining nanoparticle-delivered senolytics with regenerative cues can enhance tissue repair and restore function. Additionally, targeted delivery methods improve treatment precision, reducing potential off-target effects. However, safety concerns remain, including transient inflammation and effects on wound healing. Although several senolytic drugs are in trials, nanoparticle-based approaches are still preclinical. With continued refinement, these nanotherapies could become key tools for rejuvenating tissues and extending healthspan.
cellular aging nanodiagnostics
As an affiliate, we earn on qualifying purchases.
As an affiliate, we earn on qualifying purchases.
Building Better Organs With Nanoscale Scaffolds

Nanoscale scaffolds are revolutionizing organ and tissue regeneration by providing a biomimetic environment that supports cell growth and differentiation. These tiny structures mimic natural extracellular matrices, guiding cells to form functional tissues. Here’s how they make a difference:
- They enhance stem cell attachment and organization, improving tissue integration.
- They deliver growth factors or morphogens directly to targeted sites, stimulating regeneration.
- They support vascularization within engineered tissues, ensuring nutrient supply.
- They facilitate recellularization of decellularized organ scaffolds, restoring organ function.
Boosting Immune Defense Against Age-Related Diseases

Nanoparticle vaccines can directly enhance your immune response by improving T-cell functionality and targeting specific infections more effectively. These advanced delivery systems help your body recognize and fight age-related threats before they cause serious illness. By boosting immune defense, nanotech offers a promising way to reduce the burden of age-associated diseases. Moreover, advanced delivery systems can also facilitate personalized medicine approaches, tailoring treatments to individual immune profiles for even better protection. Additionally, targeted vaccine delivery leverages nanotechnology to improve vaccine efficacy and reduce side effects, further advancing longevity strategies. Incorporating landscaping elements such as natural barriers and shaded areas may further support overall health and well-being by creating stress-reducing environments. Advances in biocompatible materials are also crucial for improving the safety and effectiveness of nanotech-based therapies. Furthermore, integrating connected health devices can monitor immune responses in real-time, enabling more dynamic and adaptive treatment plans.
Nanoparticle Vaccines Boost Immunity
Boosting immune defense against age-related diseases is a promising approach made possible by nanoparticle vaccines. These vaccines enhance immunity by targeting specific immune pathways and improving delivery efficiency. Here are four ways they do this:
- They deliver antigens directly to antigen-presenting cells, boosting the body’s recognition of pathogens and cancer cells.
- Surface modifications allow nanoparticles to target immune cells more precisely, increasing vaccine effectiveness.
- Nanoparticles facilitate sustained release of immune stimulators, promoting longer-lasting protection.
- They enable repeated, low-toxicity doses for immune reprogramming without overwhelming the system.
This targeted approach helps counteract immunosenescence, reducing susceptibility to infections and age-related diseases. With nanoparticle vaccines, you can potentially strengthen your immune system to better fight off health threats as you age.
Enhancing T-cell Functionality
As we age, T-cell function declines, weakening the immune system’s ability to fight infections and combat age-related diseases. Nanotech offers promising strategies to reverse this decline by delivering targeted therapies. Nanoparticles can transport cytokines, growth factors, or gene-editing tools directly to T-cells, boosting their proliferation and responsiveness. Surface-functionalized nanocarriers can selectively target exhausted or senescent T-cells, reactivating their immune capacity. Additionally, nanotech-enabled vaccines can enhance T-cell activation against pathogens and cancer cells, improving immune surveillance. These approaches aim to restore a youthful T-cell profile, reducing infection risks and lowering chronic inflammation. Furthermore, advances in nanoparticle targeting improve the precision and safety of these therapies, addressing previous limitations in systemic delivery. The development of targeted delivery systems is essential for increasing the efficacy and reducing potential side effects of nanotech-based treatments. Improved delivery precision can also minimize off-target effects and improve overall treatment outcomes. As research progresses, integrating immune system rejuvenation strategies with nanotechnology holds great potential for extending healthspan. By combining these nanotech approaches with personalized medicine, researchers can tailor treatments to individual immune profiles, maximizing effectiveness. While challenges remain—such as safe systemic delivery and long-term biocompatibility—these innovations could markedly strengthen your immune defenses as you age.
Targeted Infection Prevention
With age, your immune system becomes less effective at preventing infections, making you more vulnerable to diseases like influenza, pneumonia, and COVID-19. Nanotech offers targeted solutions to boost your defenses: 1. Nanoparticles can deliver vaccines directly to immune cells, enhancing their response. 2. Surface-functionalized nanocarriers target infected or vulnerable tissues, improving drug precision. 3. Nanosensors detect early infection biomarkers, enabling prompt intervention. 4. Nanoparticle-based immunomodulators reprogram immune responses for sustained protection. These innovations help maintain immune resilience, especially in tissues where traditional treatments struggle. Additionally, the development of targeted delivery systems ensures that therapeutic agents reach specific sites, minimizing adverse reactions and maximizing efficacy. The incorporation of luxurious fabrics and intricate craftsmanship in nanotech-enhanced medical devices could revolutionize patient comfort and compliance. Moreover, personalized medicine approaches utilizing nanotechnology could further tailor treatments to individual immune profiles. By focusing delivery and early detection, nanotech minimizes side effects, reduces infection risks, and supports healthier aging. This targeted approach could markedly extend your ability to fight infections as you age, leveraging advances in clinical research to optimize outcomes.
Ethical Boundaries and Safety Challenges of Nanotech Longevity

As you explore nanotech’s potential to extend lifespan, you need to consider the long-term safety uncertainties, like nanoparticle accumulation and unforeseen health effects. You also face questions about fairness, as access to these advanced therapies could widen existing inequalities. Without strong regulations and oversight, these ethical and safety challenges might hinder responsible development and public trust. Additionally, understanding the safety benefits of glycolic acid in skincare highlights the importance of rigorous testing and regulation to ensure consumer well-being. Moreover, implementing ethical frameworks can guide the responsible development of nanotechnology to address societal concerns effectively. Establishing regulatory standards based on scientific evidence is essential to mitigate risks and foster public confidence in these emerging technologies. It is also crucial to consider long-term health impacts associated with nanoparticle use to prevent unintended consequences.
Long-Term Safety Uncertainties
The long-term safety of nanotech-based longevity interventions presents significant uncertainties that challenge their ethical acceptance and widespread adoption. You might worry about unintended consequences that emerge over time, such as:
- Nanoparticle accumulation in tissues, leading to chronic toxicity or interference with normal cell function.
- Off-target gene editing or reprogramming causing mutations or tumor formation.
- Persistent immune responses or inflammation from repeated nanomaterial exposure.
- Ecosystem impacts or unforeseen epidemiologic effects if extended lifespans alter population dynamics.
These risks highlight gaps in our understanding of long-term biocompatibility, environmental effects, and safety regulation. As you consider nanotech’s promise, it’s essential to recognize that addressing these uncertainties requires rigorous testing, ongoing monitoring, and ethical oversight before widespread use.
Equity and Access Issues
Are nanotech-based longevity therapies truly accessible to everyone, or will they deepen existing health disparities? These advanced treatments are likely to be costly and complex, making them accessible mainly to the wealthy or those in developed countries. Without deliberate policies, they could widen the gap between socioeconomic groups, leaving vulnerable populations behind. High costs, specialized infrastructure, and limited healthcare resources could restrict widespread adoption. Additionally, disparities in education and healthcare access might prevent underserved communities from benefiting. To ensure fairness, policymakers and scientists must prioritize equitable distribution, affordable pricing, and global collaboration. Otherwise, nanotech’s promise of extending healthy lifespan risks becoming a privilege for the few, exacerbating social inequalities rather than promoting universal health benefits.
Regulatory and Oversight Gaps
Regulatory and oversight frameworks currently lag behind the rapid advances in nanotech for longevity, creating significant ethical and safety challenges. You need to understand these gaps to navigate the risks effectively. Here are four critical issues:
- Insufficient safety testing: Long-term effects of nanomaterials, like accumulation and toxicity, remain poorly understood.
- Lack of standardized regulations: No clear global standards exist for manufacturing, quality control, or clinical approval.
- Monitoring and enforcement gaps: Oversight agencies struggle to track and regulate emerging nanotech therapies, risking unapproved applications.
- Ethical dilemmas: Questions about equitable access, consent, and unintended consequences lack exhaustive frameworks.
Addressing these gaps requires proactive policies, global collaboration, and rigorous research to ensure safe, ethical deployment of longevity nanotech.
The Road Ahead: From Science Fiction to Realistic Therapies

Advances in nanotechnology are transforming the once-fantastical idea of extending human lifespan into a tangible scientific goal. You can expect targeted cellular repair using nanoparticles to correct genetic mutations and restore tissue function, moving beyond speculative fiction. Emerging nanodevices will enable real-time detection of aging biomarkers, allowing personalized, timely interventions. Senolytic nanoparticles aim to clear dysfunctional cells, potentially reversing tissue decline, while nanostructured scaffolds support organ regeneration. Immune rejuvenation through nanocarriers promises to restore youthful immune responses and improve cancer surveillance. Although challenges remain—such as ensuring safe delivery, long-term biocompatibility, and regulatory approval—the pathway from promise to practical therapy is narrowing. With continued innovation, nanotech therapies could soon become realistic tools to extend healthspan and combat aging.
Frequently Asked Questions
How Soon Could Nanotech Therapies Realistically Extend Human Lifespan?
You could see some nanotech therapies that extend lifespan within the next decade or so, especially those targeting age-related diseases and tissue repair. Advances in nanodiagnostics, senolytic delivery, and immune rejuvenation are progressing rapidly, but widespread, effective longevity treatments will still need more research, safety validation, and regulatory approval. Realistically, significant lifespan extension might become available in the next 10 to 20 years, though true immortality remains unlikely anytime soon.
Are Nanotech Interventions Safe for Repeated or Lifelong Use?
Are nanotech interventions safe for repeated or lifelong use? While promising, they still carry risks like nanoparticle accumulation, chronic inflammation, and off-target effects. Can we really predict long-term safety without extensive studies? You should know ongoing research aims to address these concerns, but real long-term data aren’t available yet. Careful dosing, monitoring, and regulatory oversight are essential to guarantee these therapies benefit you without unforeseen harm over time.
Will Nanotechnology Worsen Healthcare Inequalities Globally?
Yes, nanotechnology could worsen healthcare inequalities worldwide. You might find these advanced therapies expensive and complex, making them accessible mainly in wealthier regions. This could widen the gap between high- and low-income populations, leaving vulnerable groups behind. Without deliberate policies, global disparities in healthcare access could grow, limiting the benefits of nanotech innovations to the privileged and deepening existing social and economic divides.
What Regulatory Hurdles Exist for Approving Nanotech-Based Anti-Aging Treatments?
You face significant regulatory hurdles when approving nanotech-based anti-aging treatments. Agencies require extensive safety data on long-term effects, biocompatibility, and potential off-target risks. You also need standardized biomarkers to measure efficacy, which are still under development. Additionally, steering through evolving guidelines for nanoparticle manufacturing and ensuring equitable access can slow approval processes. These challenges demand rigorous testing, clear regulatory pathways, and international cooperation to bring safe, effective nanotherapies to market.
Can Nanotech Prevent or Reverse All Types of Age-Related Diseases?
You might think nanotech can reverse all age-related diseases, but it’s unlikely. Currently, over 100 age-related conditions, like Alzheimer’s or osteoarthritis, involve complex, multifactorial mechanisms that nanotech can only partially target. While nanodevices and nanoparticles show promise in repairing cells, clearing senescent cells, and boosting immunity, complete reversal remains a scientific challenge. You should see nanotech as a powerful tool, yet not a universal fix for every age-related disease.
Conclusion
As you explore the world of nanotech and longevity, remember it’s like charting a course through uncharted waters—full of promise and uncertainty. While these tiny marvels could someday turn back the clock, it’s up to us to navigate ethical and safety challenges wisely. With each breakthrough, you’re stepping closer to a future where aging might be just a chapter, not the end of your story. The journey toward immortality is just beginning.